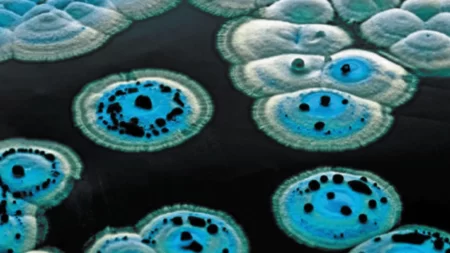

Después de ocho embarazos, Victoria de Inglaterra, decidió abogar por el sexo femenino y luchar en contra de la tradición católica del parto con dolor, para transformarlo en una experiencia más placentera y menos traumática para la madre.
«El dolor del parto no debe ser eliminado»
Era lo que decían las sociedades médicas de la época. Todos los procedimientos médicos implicaban dolor, no existía la anestesia y los pocos médicos que intentaban controlar los dolores de sus pacientes eran criticados y señalados.
Todo el proceso de evitar el dolor, comenzó en Estados Unidos, un odontólogo utilizaba eter para aliviar la angustia de sus pacientes y aligerar el dolor. La noticia se propagó rápidamente por Europa como algo extraordinario y el médico Edimburgo James Young Simpson, decidió probar su propia versión.
No estaba totalmente convencido de que el éter fuera una buena opción, pero descubrió que el cloroformo, en medidas controladas ayudaría muchísimo a las mujeres en trabajo de parto -que era su principal preocupación-.
¿Un castigo divino? «Parirás a tus hijos con dolor»
La sociedad médica no era la única que estaba en contra del uso de químicos para aliviar el dolor del parto, los religiosos enseguida comenzaron a atacar demostrándo que en las sagradas escrituras del catolicismo, específicamente en el Génesis, decía que la mujer «parirá a sus hijos con dolor», como parte de un «castigo divino.»
Edimburgo James Young Simpson, pensaba que toda la situación era completamente absurda y para sacarse a la iglesia de encima, alegaba que Dios había dormido a Adán cuando le quitó la costilla para crear a Eva. No lo habría hecho en carne viva para hacerlo sufrir.
La reina rebelde que logró cambiar todo
Nadie parecía apoyar las ideas revolucionarias de Edimburgo Simpson, solo unos pocos médicos, esto evitaba que su solución se propagara así que las mujeres continuaban dando a luz sumergidas en un terrible umbral de dolor. Todo esto cambió cuando la reina Victoria de Inglaterra, iba por su 8vo embarazo.
¿Cómo se enteraron los reyes? La reina de Inglaterra ya había dado a luz a 7 hijos y en cada parto había sufrido enormemente. Ya no estaba muy joven (33 años) y su cuerpo estaba deteriorado. Con miedo de sufrir otra vez, buscó incansablemente alguna solución, hasta que dio con la teoría del éter e invitó a John Snow -uno de los discípulos de Edimburgo- para que la anestesiara.
Todo el cuerpo médico del palacio estaba en contra, pero la decisión era irrevocable, Victoria de Inglaterra necesitaba aliviar su dolor y dar a luz con comodidad. Y asi fue.
¿Cuál era el método? En un pequeño pañuelo se agregaban unas cuantas gotas de cloroformo, en cada contracción la Reina aspiraría el pañuelo y quedaría en estado de trance. Las cantidades eran mínimas pero funcionaban. Después de solo 53 minutos, dio a luz a su hijo sin problemas. -Los partos anteriores se habían tardado más de 9 horas-.
Una decisión más justa para las mujeres
Cuando la mismísima Reina de Inglaterra tomó la decisión de utilizar anestesia en su parto y demostró que los resultados fueron favorables, la noticia recorrió el mundo. Las sociedades médicas seguían quejándose pero era mayor la curiosidad por analizar si realmente funcionaba.
La iglesia por otro lado seguía considerándolo una aberración a la naturaleza y continuaba en contra, pero a nadie parecía importarle.
Las mujeres comenzaron a utilizar anestesia en sus partos y el dolor ya no formaba parte del procedimiento -o al menos no tanto como antes-. La Reina utilizó anestesia en su último parto y en agradecimiento nombró a John Snow como Sir de Inglaterra, un título muy importante de la época.
Fuente: culturizando.com